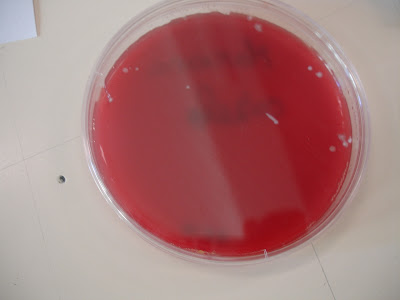

quinta-feira, 23 de dezembro de 2010
quarta-feira, 15 de dezembro de 2010
La Sylphide
Hoje vamos ao Teatro Nacional de S. Carlos assistir ao Bailado “La Sylphide” que conta a história do jovem escocês James que estava noivo de Effie.
Mas, no dia do casamento, James abandona a noiva porque se apaixona por uma sylphide, um ser alado da floresta.
Uma bruxa chamada Madge vê que os dois estão mesmo apaixonados e dá um lenço mágico a James. Explica-lhe que se ele amarrar o lenço na cintura da sylphide as suas asas cairão e desse modo ela não poderá voar mais.
Quando a sylphide coloca o lenço, cai morta no chão.
As outras sylphides e os amigos levam James de regresso ao seu mundo e ele descobre que Effie se vai casar com outro homem.
Furioso, James enfrenta Madge que acaba por o matar.
Eu gostei muito do bailado porque achei que os bailarinos dançaram muito bem.
Inês A.
Eu gostei de ver o bailado “La Sylphide” porque foi um grande diversão. Gostei quando a bruxa Madge mostrou os dentes podres.
Daniel
Eu gostei de estar num camarote a ver o bailado “La Sylphide” e eu senti que também tinha que dançar assim.
Margarida P. B.
Eu gostei porque estava bem feito. As roupas estavam muito bonitas.
Hugo
Eu gostei muito, muito, muito de ver o bailado porque eu achei que foi muito giro.
Gonçalo
Eu gostei quando a bruxa matou o James.
André
No bom bailado “La Sylphide” eu adorei a história. Acho que está muito bem construído e gostei do intervalo quando a senhora disse que o nome da personagem principal era Jacinto e chegou lá um escocês que disse que o seu nome era James.
João
Eu gostei da parte em que os bailarinos estavam em casa a dançar.
Margarida B.
Eu não gostei da parte em que a bruxa matou o James. Eu gostei da parte em que o irmão de james casou com a Effie. Eu gostei de ir ao Bailado. Foi muito giro.
Obrigada
Beijinhos da sala 5
Beatriz P.
Eu não gostei porque eu não percebi.
Eduardo
Eu gostei quando o James estava a dançar e lhe vi as cuecas por baixo da saia.
Gaspar
Eu gostei porque senti que era bonito. Era apaixonante acima de tudo.
Beatriz G.
Os nossos desenhos
 (desenho de João)
(desenho de João) (desenho de Eduardo)
(desenho de Eduardo)
(desenho de Beatriz G.)
terça-feira, 14 de dezembro de 2010
Coro Pais & Filhos
quinta-feira, 9 de dezembro de 2010
Coro da Festa de Natal
O traje vai ser:
MENINOS - calça de ganga e camisa branca
MENINAS - saia de ganga lisa, meias vermelhas e camisola branca
Pedimos a todos os meninos e pais (que cantem) que tragam um barrete de Natal (podem arranjar nas lojas chinesas).
Qualquer problema podem falar comigo.
Bons ensaios
Filipa Somsen (mãe do Henrique)
Problema para toda a família (7)
O Pai Natal tem 5 renas (a Fiúsca, a Pantufa, a Dourada, a Luzinha e a Sorrisos) que puxam o trenó do Pai Natal aos pares.
Quantos pares de renas consegue o Pai Natal fazer com estas 5 renas?

Ver soluções anteriores
Problema dos números da árvore de Natal
problema do algarismo 2
problema "Quantos telefonemas?
sábado, 4 de dezembro de 2010
Computador Magalhães
Problema para toda a família (6)

Usando apenas os números de 1 até 9, sem os repetires, tenta colocá-los dentro das estrelas de modo a que a soma de cada lado da árvore de Natal seja 20.
Soluções






 Árvores de Natal decoradas por Vinícius
Árvores de Natal decoradas por Viníciusdomingo, 28 de novembro de 2010
Problema para toda a família (5)
Quantas vezes escreveu o algarismo 2?
Problema retirado do site http://www.escolovar.org/problemas_numeros.misteriosos.htm
Solução
Pintámos os números numa tabela e chegámos à conclusão de que escrevemos 20 vezes o algarismo 2.
Para escrever o número 2 usamos duas vezes o algarismo 2.
(O Vinicius descobriu a armadilha...)
quinta-feira, 25 de novembro de 2010
Ópera “Hänsel e Gretel”
 (Desenho de Henrique)
(Desenho de Henrique)No dia 23 de Novembro, fomos ao Teatro Camões assistir à Ópera “Hänsel e Gretel”.
Nós viajámos de autocarro alugado pela Junta de freguesia de S. José, acompanhados pela Raquel, pelos pais e irmã da Joana e pela avó da Inês A..
A versão da história foi um bocadinho diferente daquela que estávamos à espera, mas foi muito divertida!
Agradecemos a todas as pessoas que tornaram possível a nossa ida à ópera mais uma vez.
Obrigado!
 (Desenho de Margarida B.)
(Desenho de Margarida B.)Querem conhecer a versão da história que vimos e ouvimos? Aqui fica um pequeno resumo.
Hänsel e Gretel
A família de Hänsel e Gretel era muito pobre. Como não tinham comida, a mãe mandou os filhos para a floresta colher amoras.
Para não se perderem, Hänsel deixou migalhas de pão pelo caminho, mas os pássaros comeram-nas.
Anoiteceu e eles não encontraram o caminho de volta. Ficaram perdidos na floresta e adormeceram. De noite, sonharam com anjos.
Na manhã seguinte, encontraram uma casinha de chocolate e apareceu a bruxa malvada. A bruxa queria assar Hänsel para o comer e obrigou Gretel a acender o forno.
A menina pediu à bruxa que lhe mostrasse como se acendia o forno e empurrou-a para dentro do forno.
No final, Hänsel e Gretel salvaram as outras crianças dos feitiços da bruxa. Apareceram os pais que estavam muito preocupados e todos cantaram muito felizes.
E agora aqui ficam outros dos nossos desenhos.
(Desenho de Inês A.) (Desenho de Vinícius)
(Desenho de Vinícius) (Desenho de Pedro L.)
(Desenho de Pedro L.) (Desenho de Sofia)
(Desenho de Sofia) (Desenho de Beatriz P.)
(Desenho de Beatriz P.) (Desenho de Gaspar)
(Desenho de Gaspar) (Desenho de Eduardo)
(Desenho de Eduardo) (Desenho de Gaspar)
(Desenho de Gaspar) (Desenho de Pedro F..)
(Desenho de Pedro F..) (Desenho de Leo.)
(Desenho de Leo.)(Desenho de Margarida P. B..)
(Desenho de Hugo.)
(Desenho de Mariana)
sexta-feira, 19 de novembro de 2010
Problema para toda a família (4)
• uma camisola amarela e uma camisola verde;
• umas calças azuis, umas calças vermelhas e umas calças cor-de-laranja.
De quantas maneiras diferentes podes vestir o ursinho?
Resolve o problema e explica como pensaste. Podes fazer o desenho das roupas do ursinho ou inventar outra maneira de explicar como pensaste.
Aqui podes experimentar um jogo sobre este problema.
(No botão “Customize” podes alterar o número de camisolas e de calças do ursinho)
sábado, 13 de novembro de 2010
Problema para toda a família (3)
Quatro alunos ganharam um concurso.
Quando souberam da notícia, telefonaram uns aos outros
para dar os parabéns.
Quantos telefonemas fizeram ao todo?
Solução
Como são 4 pessoas, e ninguém dá parabéns a si próprio, alguns meninos pensaram que eram necessários 12 telefonemas (3 x4=12).
Parecia certo, mas outros meninos lembraram que se uma pessoa telefona a um amigo para lhe dar os parabéns, o amigo aproveita a mesma chamada e também lhe retribui os parabéns.
sexta-feira, 12 de novembro de 2010
O Magusto na Escola
No dia 11 de Novembro de 2010 foi o dia do magusto e nós fizemos uma festa na escola. O meu pai Fernando e a minha avó Rosa vieram à festa e comeram bolos e castanhas.
Foi uma grande festa!
Depois fiquei com sono, fui para casa, tomei banho e fui para a cama.
No dia 11 de Novembro de 2010 (dia de S. Martinho) cá na escola, festejámos fazendo um magusto. A festa começou às 5h e depois nós íamos embora quando quiséssemos.
Assámos castanhas (os pai e as auxiliares, claro!) e cantámos uma canção chamada "Ai vamos assar castanhas" e, ainda jogámos muito, muito, muito, muito à bola.
Na quinta-feira foi dia de S. Martinho e fizemos um desenho para enfeitar o muro e muitas mais actividades. Também cantámos uma canção.
Havia muita comida em cima das mesas e havia muitas pessoas.
Foi tão divertido!
Na quinta-feira, dia 12 de Novembro, houve uma grande festa e houve bolos, castanhas, batatas fritas e rebuçados.
Depois fui jogar à bola e fui brincar com a Beatriz G. e com o Hugo.
quarta-feira, 10 de novembro de 2010
Texto da Sofia

No sábado, eu fui a um treino de futebol com os meus pais e irmãos.
O treinador, que é o senhor Vítor, inventou regras especiais para este jogo:
- Um golo das raparigas valia 5 pontos e um golo dos rapazes valia 1 ponto;
- As raparigas podiam tirar a bola aos rapazes, mas o contrário não.
Eu era capitã de uma equipa e tinha 5 jogadores.
A minha irmã Maria era capitã da outra equipa com 4 jogadores.
No fim, o resultado foi 7 a 5. Ganhou a minha equipa.
10-11-2010
Sofia
Texto trabalhado por todos no dia 9/11/2010
sábado, 6 de novembro de 2010
Problema para toda a família (2)
Porém, o seu barco só lhe permite levar um acompanhante de cada vez, fazendo com que sejam necessárias várias viagens.
Além disso, a ovelha não pode ficar sozinha com a couve, nem o lobo pode ficar sozinho com a ovelha.
Como é que o pastor há-de resolver este problema?

sexta-feira, 5 de novembro de 2010
As nossas bactérias
 Hoje vimos o resultado da experiência que preparámos na terça-feira.
Hoje vimos o resultado da experiência que preparámos na terça-feira.A cientista Margarida voltou à nossa sala para nos mostrar o crescimento das amostras de bactérias que recolhemos há três dias atrás (ver aqui).
Vimos colónias de bactérias com várias formas e feitios... Umas são mais perigosas que outras.

Aprendemos que é muito importante cuidarmos da higiene do nosso corpo para não ficarmos doentes por causa das bactérias e dos outros micróbios.






















